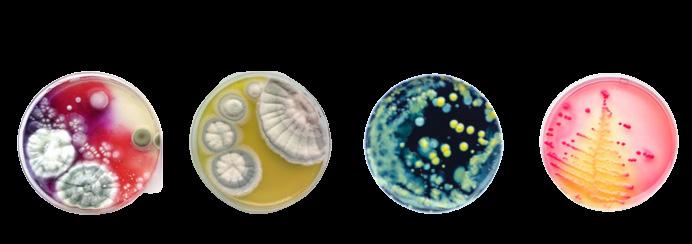

Education / DIPLOMA IN DESIGN (OBJECT & JEWELLERY)
Nanyang Academy Of Fine Arts
2019-2023
Extracurricular Activities /
AFGHAN MALAYA TRADING COMPANY (AMTC)
Intern
August 2022 - November 2022
Jewellery designer
Handling diamonds and gemstones

Education / DIPLOMA IN DESIGN (OBJECT & JEWELLERY)
Nanyang Academy Of Fine Arts
2019-2023
Extracurricular Activities /
AFGHAN MALAYA TRADING COMPANY (AMTC)
Intern
August 2022 - November 2022
Jewellery designer
Handling diamonds and gemstones
Skills / Project Management (MS Office 365)
3D Modelling ( Lightroom, Keyshot, AutoCAD, Rhino 3D, Technical Drawing, Model Making, Prototype Making, Metalsmithing, Woodwork, Wirework, Enameling, Gemology, Photography)
Graphic Design (Adobe Illustrator, Adobe Photoshop, Adobe InDesign, Procreate)
Fast learner, Communication, Teamwork, Leadership, Deadlines, Empathy, Project Planning, Working Under Pressure
AKOYA PEARL GRAND PRIX
Participant
May 2022
Design jewellery using 1 baroque Akoya pearl on provided theme:
“Moonlight”
SINGAPORE CREATOR AWARDS (SG ENABLE)
Participant
May 2021
Design restaurant based products/facilities to be inclusive of the physically challenged
AKOYA PEARL GRAND PRIX
Participant
April 2021
Design jewellery using 10 Akoya pearls on provided theme:
“Connection”
LUZERNE X NAFA
Semi-Finalist
September 2020
Illustrate plate and bowl designs based on topic: Singapore heritage
A dedicated 19 y/o product and jewellery design graduate, with 4 months work experience as an intern in the diamond, gemstone and jewellery industry. During the course of my academics, I was able to gain experience in exhibition, retail, customer service, health and community service, and animal welfare through participation in part-time jobs and volunteering alongside my studies.
My path into the design industry is driven by my desire to help people and my interest in functional aesthetics. Through my academics and professions, I have had the privilege to learn valuable professional and interpersonal skills such as communication, time management, and active creativity.
Needless to say, I am always on the lookout for new, challenging and exciting opportunities focused around the design community that values refinement which may benefit a person’s life.

A fishing game where the base revolves and the fish open and close their mouth. The user has to try to hook the fish and pluck them out using the fishing rod before they close their mouth again! The game is accompanied with music.
Aquatic food chain:


Foam models

Hook mechanism:



Technical dwgs

Project Brief: To re-imagine a childhood toy
Materials: Birch plywood, Acrylic paint
Synopsis: A toy designed for kids aged 4-10 years that aims towards cognitive enhancement by hooking the fish in order of the oceanic food chain while also developing a child’s pincer grasp and upper body strength.
Inspiration
Wave motion:






Technical dwgs

Blue foam models


Perspective views

Project Brief: To produce a door handle using the theme - “flow”
Materials: Jelutong wood
Synopsis: Inspired by the motion of the sea at low tide, the idea is carried out by incorporating art nouveau inspired arches and curves into the form. The door handle is designed to evoke feelings of serenity and completion
Inspiration









Project Brief: To re-imagine the design of chopsticks
Materials: Balsa wood, Acrylic paint
Synopsis: A pair of chopsticks designed for kids aged 2-5 years old disguised inside a stacking game with illustrations of common Asian food, aimed to spread awareness of Asian culture among young minds.





Project Brief: To produce a mouse design using Rhino 3D modelling
Materials: Rhinoceros Software, Adobe Photoshop, KeyShot
Synopsis: An elegant computer mouse whose color scheme and pattern is inspired by the serenity of koi fish in a pond.





Project Brief: Designed for Falco Pearl: Grand Prix 2022 competition. To produce a piece of jewellery using the theme - “moonlight”
Materials: 1 Gray Baroque Akoya Pearl, Silver
Synopsis: The pendant design takes its inspiration from the Japanese yoji-jukugo: Kachou Fuugetsu that reads Flower, Bird, Wind, Moon and means “Experience the beauties of nature, and in doing so learn about yourself”.
Inspiration

Technical dwgs

Perspective views

Project Brief: To produce jewellery using a combination of hardware materials and metalsmithing
Materials: Wall buffers, Steel washer rings, Metal (aluminum, copper, brass) wires, Copper plates
Synopsis: The set of 3 brooches is designed to mimic the diverse, colorful and erratic nature of fungus found in laboratory petri dishes. The pieces embrace a sense of amorphousness within structure. The fluidity of the fungus is delivered through the subtle movability of the various elements.
Inspiration



Technical dwgs


Render paint-up









Project Brief: To produce a ring with an unconventional, non-traditional stone setting inspired by joinery
Materials: Silver, Princess cut Green quartz, Round Citrine, Round Rhodolite garnet
Synopsis: The ring displays a princess cut green quartz held in a setting inspired by the joinery in ceiling lights and 2 round stones held in traditional tube settings. The ring is designed to bring forth the essence of purity, fantasy, and joy: elements that fuse to evoke the vigor of winter.
Fingerprints make us unique. Fingerprints are similar to cuttlefish bone texture.












Project Brief: To explore cuttlefish bone casting
Materials: Silver, Cuttlefish bone
Synopsis: The casted piece conveys the message that love is unique to each person just like the pattern formed by each cuttlefish bone is one of a kind.
Technical dwgs


Brainstorm:



Project Brief: Designed for Falco Pearl: Grand Prix 2021 competition. Produce a piece of jewellery using the theme- “connection”
Materials: 10 Akoya pearls, Silver
Synopsis: The silver pendant displays the innocence of spring that brings with it blossoming Sakura flowers, bees and honey; all connected by the singular element of nectar.


Amethyst baguette gemstone to represent lilac flowers



Copper metal to represent soil






Organic ring shape to represent nature and flow



Project Brief: To produce a ring using traditional gemstone setting
Materials: Amethyst baguette, Copper
Synopsis: The ring displays an amethyst baguette gemstone set using a traditional claw stone setting. The brown of the copper metal accompanied by the violet of the amethyst was chosen to remind the wearer of the calmness brought by a field of lilacs.

Project Brief: Exploring Chinese ink painting
Materials: Ink, Brushes, Sponges
Synopsis: The painting is inspired by the migrating bisons in the Savannah.

Project Brief: Exploring lino print
Materials: Linoleum sheet, Carving tools, Ink, Paper
Synopsis: The lino print depicts Japanese folklore’s lantern ghost- Chochin Obake.

Project Brief: Exploring mixed media in contemporary art
Materials: Cocoa powder, Ink, Talcum, Coconut oil
Synopsis: A contemporary art piece that explores abstraction using mixed media, created in fusion of 2 of my passions- baking and art.

Project Brief: To produce a monochrome chiaroscuro drawing
Materials: White charcoal, Black paper
Synopsis: The drawing showcases a scene from the popular film “The Great Gatsby” (2013) capturing the female protagonist - Daisy.